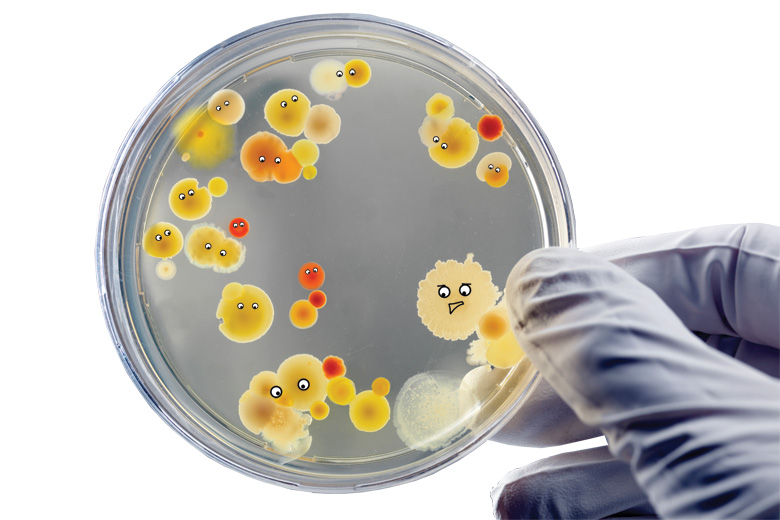

For academic scientists, the transition from postdoctoral researcher to group leader is arguably the toughest step that they will ever take. From the camaraderie and intense research focus of doctoral and postdoctoral work, new principal investigators suddenly acquire myriad supervisory, administrative and strategic responsibilities that push many far outside their comfort zones and leave them feeling alone and out of their depth. Here, eight established scientists at varying levels of seniority give their advice on how to make a success of the “boss” experiment.
Conflict within the lab will be a given, and you should read up on interest-based conflict resolution
It is quite shocking to find yourself as the lab head. The easy camaraderie of postdoc days will seem far away and, in the excitement and confusion, you may want to isolate yourself. Resist the urge. Put yourself out there, even when you are uncomfortable – it’s a good time to work on communication skills as you get your science going.
Go to seminars and volunteer to give them; don’t wait until you have results. Get to know the research of everyone in your field – not just the broad outlines but the details – and how it fits into the wider picture. Ask questions, take notes. Watch to see who gives the best talks, who seems most prepared, who treats her people well and who garners the most respect. It is important at every stage to find mentors to help you through the scientific, professional and personal aspects of running a lab, and getting inspiration from role models is a first step in building a network of connections.
You should also meet with the head of your department and find out what the real tenure or promotion requirements are. Embrace them: alongside your values, they will form a framework for your lab and research. Introduce yourself to the folks in human resources and other administrative departments whose help you cannot do without, and listen to their advice in organising your lab. Then start bringing your trainees into your network. Be open about everything involved in becoming a scientist. Authorship, ethical behaviour, writing and reading grants, managing funds, meeting people at conventions: teach everyone everything that can help make a successful scientist.
Don’t be cavalier about safety regulations, as that may suggest that you don’t care about your people. When you run meetings, take charge and be sure that they are effective: stick to an agenda, encourage everyone to contribute and follow up on action points.
It might be a while before your group has the critical mass needed for fruitful lab meetings, so it can make sense to hold joint meetings with another recent starter, or someone in a similar field. With supportive people, your trainees will learn to analyse data and to give and take constructive criticism.
Journal clubs are important too. Giving a talk on a solid paper with interesting data can not only teach (with guidance) what makes a good paper, but it also allows trainees to learn to give a good talk and to hear criticism without the emotional burden of presenting their own data.
You also need to learn to take constructive criticism yourself, and to keep your emotions under control. Losing your temper with your trainees – or, conversely, being excessively friendly towards them – is unfair because the unequal power dynamic does not allow them to be similarly free with their emotions. It will cause resentment and it may be years before another student ventures to do even a rotation in your lab.
Conflict within the lab will be a given, and you should read up on interest-based conflict resolution. One of the main reasons lab cultures go bad is that the lab head won’t step in when there is a personnel or personal problem among members. The sooner you are comfortable with negotiating the deeper interests that lie beneath the conflict, the sooner your people can trust that you have their futures in mind.
At the end of their careers, many scientists find that tenure and awards mean much less to them than the relationships they have made, and the successful trainees that they have mentored. So don’t wait to realise the power, impact and privilege you hold. While you do need to meet basic tenure and promotion requirements, you don’t need permission to do science the way that you want to. Consider yourself not only as a scientist and the head of a lab but as a mentor and global citizen, and act always with integrity.
Kathy Barker is clinical assistant professor at the University of Washington School of Public Health and author of At the Helm: Leading Your Laboratory.
A person who fails to come up to scratch after training will only hurt your progress. Having nobody is better than having a bad body
Five years into my independent career, I could offer new starters some advice. One piece would be not to sweat the small stuff. But, on the other hand, I know that if I were to hit the rewind button, that initial angst would be the same. Nothing erases the early anxiety except individual experience.
Shortly after starting out, I was fortunate enough to attend the annual three-day training programme in lab management for young group leaders held at Cold Spring Harbor Laboratory on Long Island, New York: something I have previously urged other institutions to emulate. Tellingly, the workshop focuses on managing relationships. People are your most valuable asset and often your most expensive. If you are worried about stocking your lab, forget it. You will inevitably make some wrong choices, but those few thousand dollars will be vastly overshadowed by what you spend on your group members, not just in funds, but also in your even more precious assets of time and energy.
The unfortunate reality is that people are not inbred laboratory mice. Each recruitment to your lab is a one-off experiment. Therefore, it is important to understand what your options are if a hire doesn’t work out for whatever reason. What are the policies, official or cultural, around students transferring to other labs? How do you let someone go?
Of course, everyone – you and your potential lab rats – would be better off striking gold the first time. But many new principal investigators suffer from what I call “warm body syndrome”: the compulsion to hire someone, anyone, because you needed results yesterday for publications/funding/tenure. But for some time you will likely be the best pair of hands in your lab, and a person who fails to come up to scratch even after you have trained them will only hurt your progress. Having nobody is better than having a bad body.
I believe strongly in trusting your gut when hiring. If you don’t get along with someone, if you aren’t excited to have them around, you risk creating a toxic atmosphere. Your minuscule start-up lab is a blank slate and each person you hire will have a disproportionately significant role in setting the tone that will determine subsequent recruitments and future productivity: your ability to teach and mentor, and, frankly, your job satisfaction.
Beyond avoiding obvious red flags and crossing your fingers, simple luck plays a part. After five graduate student recruitments, two of whom have graduated, I feel very lucky, but I am also still surprised by the vastly different obstacles that each student faces, and I continue to struggle with finding the most effective ways to help each one.
Besides seeking advice from your peers, senior colleagues and even your mum, there is a key self-teaching aspect. Keep records of how things are going with each lab member, ask them for input into their own training and development, solicit feedback on their experiences when they leave and remember to step back and self-evaluate.
If there is one thing I took away from the Cold Spring Harbor workshop, it’s that there are always at least two people in the conversation. In a mentor-mentee or employer-employee relationship in particular, the person facing you is often trying to take cues from you. You are also your own one-off experiment, so collect the data and evaluate it critically, just like you were trained to do.
Jessica Seeliger is assistant professor in the department of pharmacological sciences at Stony Brook University, New York.
You need someone senior to look out for you; find someone simpatico
What was the most helpful advice I got when starting my group? There is no answer to that question because, like most of my colleagues, I didn’t get any. I got the keys to the lab, a nice pub lunch, a PC, a small amount of start-up money and a seat in a shared office in which the most commonly used word was “fuck”.
But while there is no disgrace in lying for comic effect, I should confess that, in reality, I did get two pieces of advice. One was a not-so-helpful recommendation to never become a PI in the first place because it was hard and getting harder. The other, much more helpful recommendation was to read Kathy Barker’s book At the Helm: Leading Your Laboratory. It is thorough and thought-provoking, and covers the whole spectrum of the academic experience from situations you will have considered to those that you will never have imagined (and hopefully will never be in).
In the absence of any further second-hand advice to pass on, here are the key things I had to learn the hard way:
Learn to say no
New staff represent a brilliant opportunity to offload unpopular lectures, roles on health and safety committees and other rubbish no one else wants to do. Do not unwittingly take on busywork in an attempt to be popular with the cool kids; otherwise you too will end up having to dump it on the next generation.
If you do say yes, do it well
Being a safe pair of hands is a valuable skill. If you can be trusted to deliver something tricky, you will raise your profile in the department. But be aware: competence can lead to an even heavier workload.
Get some top cover
From providing lab space and access to equipment, to mentoring and speaking up for you on promotion committees, you need someone senior to look out for you; find someone simpatico.
Build a brand
A dirty word in academic circles, but important. It’s a big and competitive world, and being known as the expert in a particular area or technique will lead to collaborations and conference invitations.
Recruit the right team (for you)
I am lucky enough to have a fantastic team. But picking the wrong people will lead to a toxic lab culture that will sink you. The first person you recruit sets the tone for the rest of your career. Get experience of interviewing by being on recruitment panels for colleagues. Think very carefully about the process, particularly the questions you ask and what characteristic they actually probe. Then choose your recruit very carefully.
Toughen the heck up
You are going to fail, often. Even well-established PIs fail. It is part of the process. Learn methods to deal with it.
Be a tiger
Remember that you earned this position on your ability; try not to let impostor syndrome overcome you.
Have fun
Academia is tough, but there are good bits: don’t forget to enjoy them.
John Tregoning is senior lecturer in the Faculty of Medicine at Imperial College London.
The one thing that really matters is to do the very best science you can
I suspect that I was given a great deal of advice during my early career from some very eminent individuals. But I remember very little of it. I was either too ill-equipped to recognise that wisdom was being offered, or too enveloped in the fog of youthful arrogance to appreciate that I was being exposed to a host of valuable experiences.
With hindsight, I bobbed about like an enthusiastic crouton on a thick soup of personal inexperience, making mistakes, rediscovering well-established knowledge and irritating senior colleagues who would mutter that “youth is doomed to repeat the mistakes of the past”. They were correct, but they should not have been exasperated. What has become very clear to me after 30 years in the business of science is that the many mistakes I made allowed me to learn, gain my own knowledge and carve out a scientific direction that encompassed my interests and capitalised on my personal strengths.
The brain of an early career scientist is not a bucket into which an older generation should too readily pour its own experience and advice. It should be more like a colander with remarkably large holes; advice should pour through it with little pause. Only occasionally should a nugget be retained for sufficient time to alter a view or change an action.
All that said, I cannot resist the temptation to lob in a few scraps of my own. My advice is straightforward; pick your battles with care. Some are simply not worth fighting: victory may bring short-term gratification – always a treat – but that can come at too great a cost in terms of wasted time and the generation of unhelpful opposition.
You will encounter irrational and stupid reviewers of your grants and papers and be tempted to release the hounds of hell upon them. But content yourself with a polite point-by-point rebuttal. You will be asked absurd questions at the end of a seminar and feel an urge to enquire whether the inquisitor has the intellect of an Orc from the mines of Moria. Instead, just answer the question they should have asked. Absurd changes will be proposed in staff meetings, but don’t waste time arguing an arcane point: just keep quiet and then do your own thing. And should you be trampled by an egotistical colleague sprinting for a Nobel prize, go home and spend time with those you love in the certain knowledge that the possession of family and friends represents a far greater prize.
The one thing that really matters is to do the very best science you can. Fight for this using every gram of your intellect and every resource and ally you have or can borrow. Stay focused on the big picture and unmask genuinely new knowledge. And take care not to become seduced by the brightly coloured buttons of fashionable technology. It is always new ideas and the power of individual creativity that matter in the end.
Russell G. Foster is professor of circadian neuroscience at the University of Oxford.

Those people who always claim to know exactly what they’re aiming at are possibly kidding themselves
There are many disadvantages to growing old – creaking joints and the need to wear spectacles, for instance. But experience can also bring comfort and a sense that things aren’t always as bad as they seem.
I learned – eventually – that there isn’t a single right way to do things, and that muddling through is not such a bad approach. As a youngster, I often felt everyone else knew the rules and it was only me that was out of my depth and liable to fall into some terrible academic faux pas that I hadn’t seen coming. Watching someone doing something I wanted to emulate – looking confident giving a talk, sounding persuasive on a committee or whatever – I found it too easy to think that since I couldn’t imagine doing it that way, I must have got it all wrong. This is a particularly pernicious problem because it is all too easy to be frozen into immobility by thinking “I couldn’t succeed at that”. So rule one is: don’t be intimidated.
The reality – another great truth to learn – is that confidence is often only skin deep. Those people you observe and admire because they are so sure of themselves often turn out to be as confused and uncertain as you are if you dig a little deeper. Perhaps the only difference is that they have decided to fake it in the hope that the imaginary will become the reality. So, rule two is: don’t be fooled by appearances.
It is also easy to be misled into believing that the rest of the world know where they are going and how they are going to get there. I have mainly moved forward by doing whatever it was that came to hand as well as I could for my own satisfaction, rather than because it was the next logical step in a carefully mapped-out career. I had fun doing this and I don’t regret it. It’s probably a good idea to have a direction of travel, and a list of criteria you’ll factor into decisions about where to go next. But I feel those people who always claim to know exactly what they’re aiming at are possibly kidding themselves. They are also quite likely to be closing off good options: chance may come knocking at their door and they won’t recognise it. So rule three is: don’t be rigid and make sure you’re enjoying what you’re doing, at least most of the time.
Finally, I would recommend that it is desirable – sometimes, at least – to take on tasks that you are not sure you are completely qualified to do. If you don’t, not only will you not discover what your strengths are but you also won’t ever acquire additional strengths. The important thing is to be willing to put in the hours to acquire the knowledge you need, and to ask for advice. Remember that asking questions is not an admission of weakness but of strength (as long as you don’t ask the same question over and over again). This is just another way of stating my rule four: don’t be afraid to take risks.
Dame Athene Donald is professor of experimental physics at the University of Cambridge and master of Churchill College, Cambridge.
I would caution against a ‘this is mine’ mentality regarding equipment or you’ll be on your own at a time of need
I don’t recall getting much advice when I began my independent career in 1994: it was expected that you’d just learn by trial and error.
Higher education was a very different world then, and it will be very different again 20 years from now. But I do think that some of the tips that I’ve picked up along the way will stand the test of time.
First, a word of caution. You’ll just not get enough experience of managing people as a new independent academic. How many years might it take until you’ve seen 10 people through a PhD? Every doctoral student is an individual with particular motivations, ways of working and modes of thought. Add in other personal aspects and you’re only getting direct exposure to a very small subset of the diversity of people you’ll work with in your career. You’ll have to develop your management and interpersonal styles based on a limited pool of experiences. But one shortcut is to read up on how people behave in organisations. Or, if you can, do an MBA or similar; I did eventually, but I wish I had done it sooner.
As a new faculty member, it is really important to seek out a mentor of global repute. If they can collaborate with you, all the better. Since you may spend many years in the same institution, it will also be useful to get to know how its economy and bureaucracy functions, so you know how to work effectively within it.
Always treat support staff as equals: apart from being the right thing to do, it will also make them much more helpful towards you. And try to make some genuine friends among your academic colleagues. These will help ease the travails of academic life and provide years of anecdotes about the idiocy and lunacy of academe. Such fellow travellers will be particularly important to you if you follow my advice and avoid dumping your work problems on your partner; it is much healthier to keep home and work life separate.
I would also caution against a “this is mine” mentality regarding equipment or you’ll be on your own at a time of need. It is hard to keep up a funding flow to support and maintain equipment, so, to even out the ups and downs, choose to work and collaborate with colleagues you can share facilities with. (And, by the way, don’t be sentimental over old kit or samples: you’ll never use them again. Only hoard or curate the most valuable.)
Don’t stop at your immediate environment when it comes to building alliances, either. Go to conferences regularly, travel, and meet more people than you think you might need to. The truth is that you can never have enough friends in science.
It is also important to recognise that certain choices will have a long-term impact on your career and life. Being an experimentalist who has built a large lab and has been the recipient of more than £10 million worth of equipment does not make me particularly mobile. So if you want to move around institutions, do so early on, or do small experiments!
Finally, always seek to be a positive disruptor. That is, try to do things that bring challenges in a positive way to your environment and the system you operate in. I confess that I had never heard of such a concept in 1994, but no system, however much it evolves, can ever have enough positive disruption – and providing it is a lot of fun.
Robert Bowman is head of the School of Mathematics and Physics at Queen’s University Belfast.

Don’t worry: we are all just making it up as we go along
I took up my first independent position – a lectureship at the University of York – in 1994, towards the end of a long recruitment drought in UK higher education that had lasted since the early 1980s. Hence, my arrival was something of a novelty in my department. This, along with the exceptionally supportive environment at York, made me feel very welcome. But it also made me apprehensive.
The transition from postdoctoral researcher to principal investigator is a big deal. There are lots of interesting career options for researchers, but, for many, moving up the academic ladder is their first choice, and it is highly competitive. This makes the postdoctoral research years full of angst about whether you will be among the chosen few.
As a result, when you finally step across the great divide, it’s very easy for a major attack of impostor syndrome to set in. For me, this was somehow amplified by my warm welcome, with its implication of high expectations. There I was, with my own office, my own phone, my own budget codes, my own lab space, and lots of departmental support structures to help me apply for grants, hire people and develop my teaching. The only thing missing was the magic wand. Surely there must be a PI’s magic wand, because becoming a PI clearly involved mythical transformation, as when Gandalf the Grey becomes Gandalf the White. So where was mine?
However, I quickly noticed that no one had one. The department was full of wonderful colleagues doing a great job, but without recourse to incantation. So my first piece of advice to new PIs is: don’t worry: we are all just making it up as we go along. You will find your way of working, and your colleagues can help you with the benefit of their diverse experience. Just ask.
My second, closely related recommendation would be not to make decisions based on fear and suspicion. Most of the advice I received as a young PI was negative, based on the idea that bad things would happen to me if I did anything other than work round the clock on my research. As a new member of staff, I would be exploited by people trying to offload their teaching and administrative work on to me.
This mindset is the antithesis of what a university is supposed to be about, and buying into it is extremely destructive. It deprives you of the community that you will draw on during the rest of your career for inspiration, support and variety. Being part of this community is why being a PI is so rewarding. That does not mean that you should say yes indiscriminately to every invitation and request, but it does mean that you should welcome opportunities and make positive decisions about which ones to take up.
Ottoline Leyser is professor of plant development and director of the Sainsbury Laboratory at the University of Cambridge.
Supporting role: departments need to consider how to induct and integrate new researchers more effectively
A successful academic career relies on relentless effort from its first day to its last. However, this effort is arguably greatest at the transition to independence, when individuals are not only initiating a research programme but also dealing with the new challenges of teaching, staff supervision, complex time management and establishing personal contacts.
In 2012, the Academy of Medical Sciences asked me to chair a task force aimed at improving support for UK biomedical scientists making the transition. It was both comforting and concerning that the list of problems faced by the hundreds of early career scientists we spoke to was virtually identical irrespective of discipline and location.
The biggest problem was career support. Many participants noted the lack of a framework for non-clinical career progression. They also felt that access to careers advice and support was highly variable across institutions, and frequently ad hoc or inadequate. In particular, there was wide agreement that departments need to consider how to induct and integrate new researchers more effectively and consistently, and to provide advice about specific procedures such as procurement, administration, workload management and even some trivial-sounding, but crucial, areas such as space management.
Researchers were also concerned about the lack of funding opportunities targeted at this career stage, and felt that there was a need for some form of national resource offering advice on elements of scientific strategy, such as establishing independence, building a group, starting collaborations and recruiting and managing staff – not to mention engaging the media.
There was also clear demand for multiple mentors at different career stages. Those with two or three years of independent experience were regarded as most able to impart current knowledge of processes and to advise on challenges relating to establishing a research group. More senior mentors were valued for their ability to advise on future career options and goals.
In the past few years, some of these issues have been addressed. Led by the Medical Research Council, a consortium has created a web-based “career framework” providing pathway maps and real-life case studies. In collaboration with the Wellcome Trust, the Academy of Medical Sciences itself has established the Springboard Awards scheme to provide small grants for newly independent non-clinical lecturers, coupled with mentoring from academy fellows and access to leadership and career development activities. The first round of the scheme recently awarded more than £1.8 million, but the huge demand demonstrated that this was but a drop in the ocean; the academy hopes to offer more in the future.
Other initiatives are required to fill the gaps. Networking could be made easier by attaching early career seminars to prominent conference series. I personally think that the whole biomedical research community – not just early career researchers – could also benefit from a national system that facilitates clinical, non-clinical and industrial interaction through visits, lab swaps and placements.
Martin Humphries is vice-president and dean of life sciences at the University of Manchester.
POSTSCRIPT:
Print headline: Your toughest experiment
Register to continue
Why register?
- Registration is free and only takes a moment
- Once registered, you can read 3 articles a month
- Sign up for our newsletter
Subscribe
Or subscribe for unlimited access to:
- Unlimited access to news, views, insights & reviews
- Digital editions
- Digital access to THE’s university and college rankings analysis
Already registered or a current subscriber?





